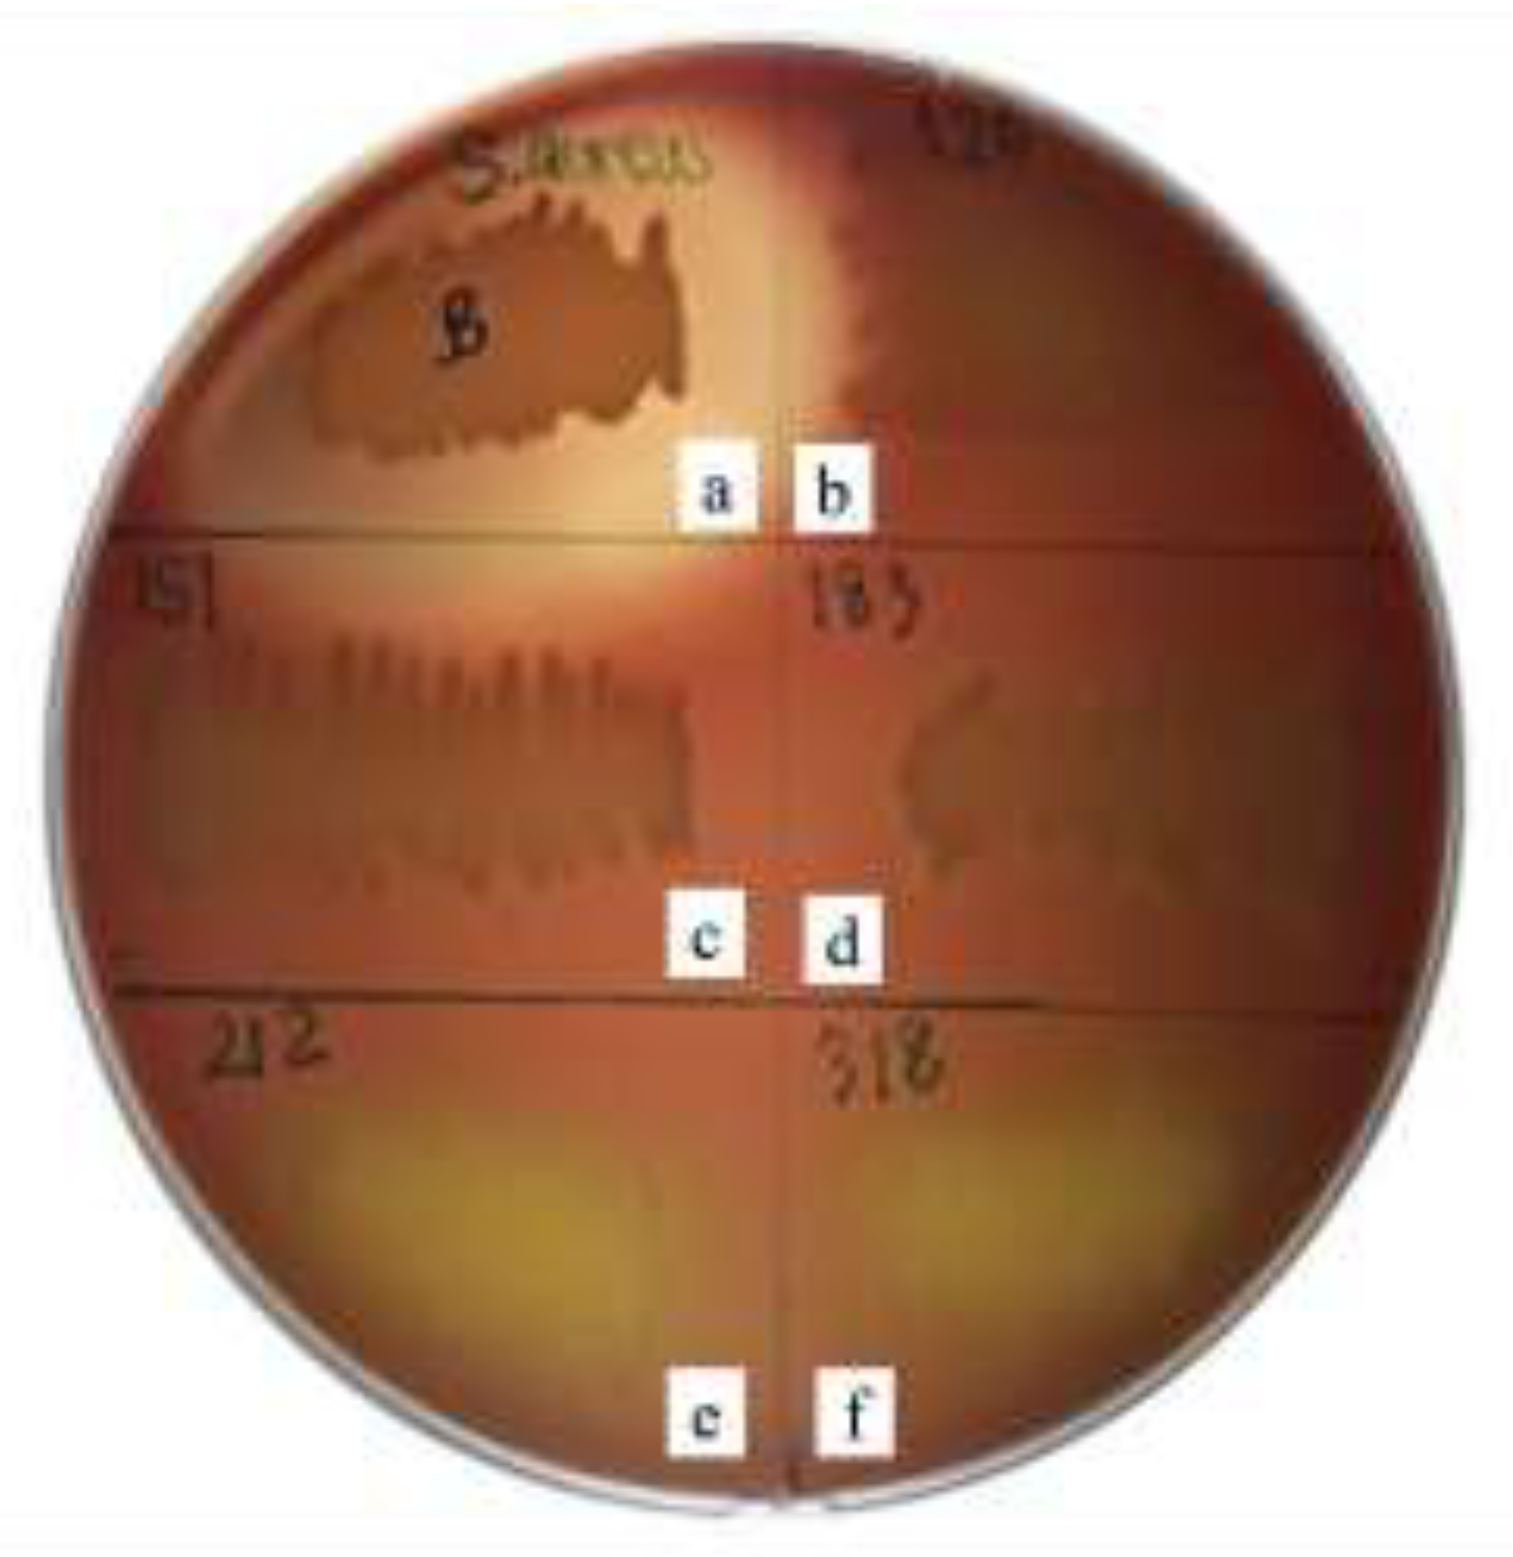
Preprints 195936 g002

1. Introduction
Escherichia coli (
E. coli) is one of the most important pathogens causing diarrhea in neonatal and weaned piglets. Piglet diarrhea leads to substantial economic losses in the swine industry due to increased morbidity and mortality, reduced growth performance, and higher veterinary costs [
1]. Prevention is generally more effective than treatment, yet traditional control strategies have relied heavily on antibiotics [
2]. This dependence has raised serious concerns about antibiotic residues in meat and the global spread of antimicrobial resistance (AMR) [
3]. As regulatory authorities and consumers increasingly demand reductions in antibiotic use, there is a growing need for sustainable alternatives that can maintain animal health and productivity without contributing to AMR [
4]. Several alternative approaches have been proposed, including organic acids, copper sulfate, zinc oxide, prebiotics, herbal supplements, and probiotics. Among these, probiotics have attracted particular attention for their ability to promote intestinal health, reduce the incidence and severity of enteric diseases, and support growth performance in pigs, while reducing the need for antibiotics [
5]. Probiotic supplementation has been shown to modulate the gut microbiota, enhance immune function, and improve nutrient utilization in swine. Recent studies have confirmed that probiotics can serve as viable antibiotic alternatives for preventing bacterial diarrhea in piglets, with benefits extending to improved feed efficiency and overall health [
6]. Moreover, probiotic use aligns with the One Health framework by mitigating AMR risks at the animal-human-environment interface [
7].
At birth, the gastrointestinal tract of animals is sterile but rapidly colonized by microorganisms from the mother and the surrounding environment. This early colonization plays a critical role in the development of the digestive system, metabolic functions, and immune competence of neonates [
8]. The gut microbiota’s composition is shaped by factors such as delivery mode, maternal microbiota, diet, and environ-mental exposure [
9]. In pigs, a diverse and balanced gut microbiota supports resistance to pathogens, adaptation to dietary changes, and improved physiological functions [
10]. The porcine gastrointestinal tract is anatomically compartmentalized, with the small intestine particularly the duodenum, jejunum, and ileum being the main site for nutrient digestion and absorption. Maintaining a healthy microbiota in these regions is critical for growth and disease prevention, especially in intensive swine production systems.
Probiotics are defined as live microorganisms that, when administered in adequate amounts, confer health benefits to the host by improving the microbial balance in the gastrointestinal tract (FAO/WHO, 2002) [
11]. Effective probiotics must survive exposure to gastric acid and bile salts, adhere to intestinal epithelial cells, and exhibit antagonistic effects against pathogens [
11]. In swine production, probiotics are used both to support growth and to prevent colonization by enteric pathogens such as
Salmonella spp.,
E. coli, and
Clostridium perfringens [
12]. Lactic acid bacteria (LAB) are among the most widely studied probiotic groups due to their non-pathogenic nature, acid and bile tolerance, and ability to produce antimicrobial substances such as organic acids, hydrogen peroxide, and bacteriocins [
13]. These antimicrobial compounds are considered safe and, in some cases, have been linked to reduced pathogen load and improved gut health in pigs [
14].
The probiotic properties of LAB are highly strain-specific, even among isolates belonging to the same species [
15]. Only a limited number of strains with strong acid and bile tolerance, adhesion ability, and potent antimicrobial activity have been identified, and their functional properties often vary depending on the host and environmental context. Recent advances in microbiome analysis and targeted isolation techniques have enabled the discovery of novel LAB strains from indigenous pig breeds and different rearing environments, some of which show promise for improving gut integrity, modulating immunity, and reducing pathogenic
E. coli colonization [
16]. However, further research is needed to characterize these strains comprehensively and assess their potential as antibiotic alternatives in commercial pig production.
Therefore, the aim of the present study was to isolate and characterize LAB with potential probiotic candidates from fecal samples of pigs at different ages raised without antibiotics or probiotics. The focus was on identifying strains that could survive under gastrointestinal conditions, exhibit inhibitory activity against pathogenic E. coli, and demonstrate other desirable probiotic traits. The findings of this work provide a basis for selecting promising LAB strains for development as feed additives to promote swine gut health, reduce reliance on antibiotics, and contribute to the global effort to mitigate AMR in livestock production.
2. Materials and Methods
2.1. Ethical Approval
Since fecal samples were collected without handling or restraining the animals, specific approval for animal use was not required. However, the experimental procedures involved the use of microbial isolates. Therefore, all microbiological work was reviewed and approved by the Institutional Biosafety Committee (IBC) of Chiang Mai University (Approval No. CMUIBC A-0763004).
2.2. Sample Collection
The study population comprised suckling piglets aged 7-30 days. The required sample size was estimated based on an assumed Lactobacillus detection prevalence of 50%, a total piglet population of 2,800, an effect size of 0.3, statistical power (1 – β) of 0.98, and an alpha error probability of 0.02, using G*Power software (version 3.1). The minimum calculated sample size was 40; therefore, 42 fecal samples were collected to ensure adequate statistical power. Samples were obtained from a commercial pig farm in Lamphun province where no antibiotics or probiotics had been used. To maximize diversity, no more than five samples were taken from any single farrowing pen. Freshly voided feces with normal consistency and yellow to brown coloration were collected from the pen floor, placed in sterile 5 mL microcentrifuge tubes (≥2 g each), and transported at 4 °C to the laboratory for processing.
2.3. Isolation of Lactic Acid Bacteria (LAB)
One gram of fecal sample was homogenized in 9 mL of 0.85% sterile saline and serially diluted (10⁻⁴ to 10⁻⁸). Aliquots (100 µL) were spread onto de Man, Rogosa, and Sharpe (MRS) agar supplemented with 0.5% CaCO₃. Plates were incubated anaerobically at 37 °C for 48 h. Colonies producing clear zones were subcultured in MRS broth to obtain pure isolates. Gram-positive, non-spore forming bacteria were retained and tested for catalase activity; only catalase-negative isolates were preserved at -20 °C in MRS broth with 20% (
v/v) sterile glycerol [
17].
2.4. Evaluation of Probiotic Properties
2.4.1. Acid Tolerance
Colonies grown on MRS agar were suspended in 5 mL phosphate buffered saline (PBS; pH 7.2) and adjusted to 0.5 McFarland standard (~1.5 × 108 CFU/mL). One milliliter of suspension was mixed with 9 mL sterile PBS adjusted to pH 2.0 or pH 3.1 using 1 N HCl. The mixtures were vortexed for 10 s and incubated at 37 °C for 3 h. Viable cell counts before and after incubation were determined by plate counting on MRS agar. Acid tolerance was expressed as the reduction in bacterial counts (log CFU/mL) com-pared with the initial value [
17].
2.4.2. Bile Salt Tolerance
Bacterial suspensions prepared as above were inoculated (1 mL) into 9 mL MRS broth supplemented with 0.3%, 0.5%, or 1% (
w/v) bile salts (Sigma-Aldrich). Control cultures contained no bile salts. Tubes were incubated anaerobically at 37 °C for 24 h. Viable cell counts were determined at 0 and 24 h, and tolerance was evaluated based on survival relative to controls. Each strain was tested in duplicate [
18].
2.4.3. Adhesion Ability to Intestinal Epithelium (Surface Hydrophobicity)
Adhesion potential was assessed by the microbial adhesion to hydrocarbons (MATH) method. Bacteria grown on MRS agar were suspended in 5 mL PBS (pH 7.2) and adjusted to 6.0 McFarland standard. Optical density at 600 nm (OD₆₀₀) was adjusted to 0.6. Three milliliters of suspension was mixed with 1 mL of xylene in a glass tube, vortexed for 90 s, and left at room temperature for 30 min to allow phase separation. The aqueous phase was carefully removed, and OD₆₀₀ was measured again. Surface hydrophobicity (%H) was calculated as:
%H = [(OD₆₀₀ before mixing – OD₆₀₀ after mixing)/OD₆₀₀ before mixing] × 100100
Controls consisted of PBS and xylene without bacteria. All assays were performed in duplicate [
19].
2.4.4. Hemolytic Activity
For safety evaluation, isolates were streaked on tryptic soy agar (TSA) supplemented with 5% (
w/v) sheep blood and incubated at 37 °C for 48 h. Hemolysis type was determined visually: β-hemolysis (clear zone), α-hemolysis (green/brown discoloration), and γ-hemolysis (no change). Staphylococcus aureus ATCC 6538 was used as a β-hemolysis positive [
20].
2.4.5. Antimicrobial Activity Against E. coli and S. aureus ATCC 6538
The agar well diffusion method was used. LAB cultures grown in MRS broth at 37 °C for 24 h were centrifuged at 4,000 × g for 5 min, and supernatants were filtered through 0.45 µm membranes to obtain cell-free supernatants (CFS). Indicator strains pathogenic
E. coli (from diarrheic piglets) and
Staphylococcus aureus ATCC 6538 were adjusted to 0.5 McFarland standard in PBS and spread onto nutrient agar plates. Wells (7 mm) were bored aseptically, and 80 µL CFS was added per well. Lactic acid (2%
v/v) served as the positive control. Plates were incubated at 37 °C for 24 h, and inhibition zones were measured in millimeters. All tests were performed in duplicate [
21].
2.5. Data Interpretation Probiotic Properties
2.5.1. Acid Tolerance
Survival at acidic pH was assessed by comparing bacterial counts (log CFU/mL) before and after incubation at pH 2.0 and pH 3.1. A reduction of less than 1 log CFU/mL at pH 3.1 was considered acceptable for acid tolerance [
22].
2.5.2. Bile Salt Tolerance
Bacterial counts (log CFU/mL) at 0 h and 24 h in MRS broth containing bile salts were compared. Strains were classified as tolerant if no significant reduction in viable counts was observed over the incubation period.
2.5.3. Surface Adhesion Ability
Adhesion potential was expressed as surface hydrophobicity (%H) calculated by the MATH assay. Higher %H values indicated stronger cell surface adhesion capabilities.
2.5.4. Hemolytic Activity
Hemolysis was classified into three types: β-hemolysis, indicating complete lysis of red blood cells and the presence of a clear zone around the colony; α-hemolysis, representing partial lysis with a green or brown discoloration surrounding the colony; and γ-hemolysis, showing no lysis or visible change in the medium. According to safety criteria for probiotic use, LAB strains exhibiting α- or β-hemolysis were considered un-suitable, whereas only γ-hemolytic strains were deemed acceptable [
23].
2.5.5. Antimicrobial Activity Against E. coli and S. aureus ATCC 6538
The antimicrobial potential of the cell-free supernatants (CFS) was assessed by measuring the diameter of the inhibition zones against
Escherichia coli and
Staphylococcus aureus ATCC 6538. The results were interpreted according to the criteria summarized in
Table 1. This approach allowed for a comparative evaluation of the inhibitory effects of different CFS preparations on the selected pathogenic strains.
Interpretation criteria modified from Sirichokchatchawan et al. (2018) [
21]
2.6. Statistical Analysis
Data were analyzed using descriptive statistics using SPSS software (IBM SPSS Statistics, 29 version). For experiments performed on a single isolate with triplicate assays, results were presented as mean values without standard deviation. Means and standard deviations were calculated and reported where appropriate to summarize the results.
3. Results
3.1. Isolation of Lactic Acid Bacteria (LAB) from Piglet Feces
From 42 individual fecal samples collected from pigs of different ages, a total of 318 bacterial colonies producing clear zones on MRS agar supplemented with 0.5% CaCO₃ under anaerobic incubation at 37 °C for 48 h were initially obtained. These colonies were preliminarily considered as potential lactic acid bacteria. Gram staining revealed that 296 isolates were Gram-positive, of which 146 were rod-shaped (bacilli), 136 were cocci, and 14 were coccobacilli. Nineteen isolates were identified as yeasts based on morphology, and three isolates could not be maintained during subculturing; both groups were excluded from further analysis.
Catalase testing of the 296 Gram-positive isolates showed that 277 were catalase negative, consistent with typical LAB characteristics, whereas 19 were catalase positive and thus removed from subsequent screening. Consequently, 135 isolates were confirmed as Gram-positive, rod-shaped, catalase negative bacteria and retained for probiotic property evaluation. For five isolates with ambiguous Gram-staining results, the test was repeated. Among these, Isolates PMvet120, PMvet151, and PMvet183 exhibited budding cells and pleomorphic morphologies, which are characteristic of yeast rather than bacterial cells (
Figure 1). Based on these morphological features and their poor growth performance in MRS broth, these isolates were subsequently excluded from further probiotic-related characterization in this study.
3.2. Probiotic Properties of Selected LAB Isolated
3.2.1. Acid Tolerance
Among the 135 LAB isolates confirmed as Gram-positive, rod-shaped, and catalase negative, only five strains PMvet120, PMvet151, PMvet183, PMvet212, and PMvet318 demonstrated acid tolerance, with a reduction in viable counts of approximately 1.00 log CFU/mL or less after incubation at pH 3.1 for 3 h. No isolates survived exposure to pH 2.0 under the same conditions. The survival rates of these five isolates at pH 3.1 are summarized in
Table 2.
3.2.2. Bile Salt Tolerance
The five acid tolerant isolates were subsequently evaluated for their ability to survive in the presence of bile salts. After 24 h of anaerobic incubation at 37 °C, all isolates maintained viable counts above 6.00 log CFU/mL in MRS broth containing 0.3% bile salts. However, when the concentration was increased to 0.5%, only isolate PMvet212 retained a viable count of 6.56 ± 0.04 log CFU/mL, indicating substantial bile tolerance. In contrast, isolates PMvet151, PMvet183, and PMvet318 exhibited counts below the detection limit (<3.00 log CFU/mL) at 0.5% bile concentration, while PMvet120 showed partial survival. At 1.0% bile salts, none of the isolates survived above the detection threshold. The survival profiles are presented in
Table 3.
3.2.3. Cell Surface Hydrophobicity (MATH Assay)
The hydrophobicity of the five selected LAB isolates was assessed using the microbial adhesion to hydrocarbons (MATH) assay with xylene as the hydrophobic phase. The results revealed considerable variation among isolates. PMvet318 exhibited the highest hydrophobicity (12.38 ± 0.03%), suggesting a relatively better ability to adhere to the intestinal epithelium. This was followed by PMvet212 (7.85 ± 0.02%), while the remaining isolates demonstrated values below 7%, indicating weaker adhesion potential. The hydrophobicity profiles are summarized in
Table 4.
3.2.4. Hemolytic Activity (Safety Evaluation)
Hemolytic activity of the five LAB isolates was assessed on tryptic soy agar (TSA) supplemented with 5% sheep blood. The results indicated that isolates PMvet120, PMvet151, and PMvet183 exhibited γ-hemolysis, characterized by the absence of any clear or discolored zones around colonies, thereby suggesting a non-hemolytic and potentially safe profile for probiotic application. In contrast, isolates PMvet212 and PMvet318 displayed α-hemolysis, evidenced by greenish discoloration surrounding the colonies, which indicates partial red blood cell lysis (
Figure 2). The presence of α-hemolysis in these isolates raises potential safety concerns and suggests that they may not be suitable candidates for direct probiotic use without further safety evaluation.
3.2.5. Antimicrobial Activity Against Escherichia coli and Staphylococcus aureus
The antimicrobial activity of the cell-free supernatants (CFS) from the five selected LAB isolates was evaluated using the agar well diffusion assay against
E. coli (field iso-late from diarrheic piglet) and
Staphylococcus aureus ATCC 6538. Among the tested isolates, only PMvet212 and PMvet318 produced distinct and measurable inhibition zones against both target pathogens. In contrast, isolates PMvet120, PMvet151, and PMvet183 demonstrated incomplete or weak inhibition against
E. coli and showed no detectable inhibition against
S. aureus. The measured diameters of inhibition zones are summarized in
Table 5.
4. Discussion
The present study identified two presumptive lactic acid bacteria (LAB) isolates of the Bacilli group from fecal samples of suckling piglets (7–30 days old) that demonstrated potential probiotic candidates. These findings are in line with earlier reports by Buasai Petsuriyawong (2011) [
22] and Dowarah et al. (2018) [
24], who successfully isolated presumptive LAB from piglet feces collected around weaning age (28–35 days). The detection of presumptive LAB at this early stage supports the well-established observation that piglet intestines are naturally colonized by
Lactobacillus spp. before weaning, which are among the most prevalent beneficial microbes in the small intestine [
25]. Colonization is strongly influenced by maternal sources, particularly sow feces, the environment, and milk, consistent with evidence from both human and porcine milk showing the transfer of probiotic microorganisms to offspring [
26]. Recent investigations further confirm that maternal microbial transfer plays a vital role in shaping early life gut microbiota composition and disease resilience in piglets [
6].
In addition to bacterial isolates, three yeast strains were also identified from the piglet feces in this study. Their ability to withstand acidic pH and bile salts is noteworthy, as yeasts are increasingly recognized as effective probiotics due to their ability to survive harsh gastrointestinal conditions. Previous works have identified
Saccharomyces boulardii and related yeast genera as promising candidates due to their acid tolerance, bile salt resistance, and ability to inhibit pathogens [
27,
28]. More recently, novel yeast strains from livestock sources have been shown to modulate immune responses and protect against enteric infections, reinforcing their potential in animal health management [
29,
30]. This suggests that while presumptive LAB remain the dominant focus of probiotic studies, cocci-shaped LAB such as
Enterococcus and yeast isolates should not be overlooked in future investigations. Although these yeast isolates were excluded in this study, they will be preserved and further evaluated in our next phase of work for potential probiotic application in pigs, following recent findings highlighting the efficacy of Saccharomyces strains in modulating gut health.
The acid and bile salt tolerance assays conducted here further confirmed strain specific variability. Out of 135 confirmed LAB isolates, only five survived prolonged exposure at pH 3.1, although none survived at pH 2.0. This is consistent with earlier findings that probiotic survival in gastric conditions is highly strain dependent [
31]. Among these five isolates, PMvet212 demonstrated superior tolerance to 0.5% bile salt, a concentration comparable to the physiological levels encountered in the small intestine. Such tolerance is crucial for probiotic viability after oral administration, as bile salts are known to disrupt microbial membranes [
32]. Recent studies have reinforced the role of bile tolerant LAB in reducing diarrhea incidence and supporting intestinal health in weaning piglets [
33,
34]. Thus, the resilience of PMvet212 under bile stress highlights its potential as a candidate strain for feed supplementation in piglets facing post-weaning stress.
Other important probiotic attributes, including adhesion ability and hemolytic activity, were also evaluated. Among the isolates, PMvet318 showed the highest surface hydrophobicity (12.38%), though this value was lower than the threshold (>40%) suggested in some previous studies. This observation highlights the multifactorial nature of bacterial adhesion, which involves not only hydrophobicity but also other factors such as auto-aggregation, extracellular polysaccharide production, and mucin interactions [
35]. Regarding safety, isolates PMvet120, PMvet151, and PMvet183 exhibited γ-hemolysis, whereas PMvet212 and PMvet318 displayed α-hemolysis. Although α-hemolysis is less severe than β-hemolysis, the presence of hemolytic activity warrants further investigation, as hemolysin genes have been identified in some Lactobacillus strains [
36]. Following current safety recommendations [
11,
37,
38], only γ-hemolytic strains are considered safe for probiotic use. Thus, while PMvet212 and PMvet318 exhibited promising functional traits, additional genome-based safety evaluations and
in vivo tests are required to ensure their suitability for probiotic applications.
Antimicrobial activity was detected in isolates PMvet212 and PMvet318, which inhibited both
Escherichia coli and
Staphylococcus aureus. These findings are noteworthy, since
E. coli is a common cause of piglet diarrhea and antibiotic resistance remains a serious issue in swine production. The inhibitory patterns observed here are consistent with reports showing that LAB inhibit pathogens through the production of organic acids and bacteriocins [
21,
31]. More recent evidence indicates that piglet-derived LAB can enhance intestinal integrity and immune function while reducing pathogen colonization [
39,
40]. The inhibition zones (10–12 mm) recorded in this study are comparable to those previously reported (11–13 mm) for Lactobacillus strains from piglets [
21], suggesting moderate antimicrobial potential typical of naturally occurring LAB. Nevertheless, further
in vivo evaluation is needed to confirm probiotic efficacy, adhesion capacity, and safety under farm conditions. Moreover, as the antimicrobial activity observed here mainly reflects acid mediated inhibition, future studies will examine both untreated and pH neutralized cell free supernatants to distinguish organic acid effects from bacteriocin-associated inhibition [
17]. These results serve as a preliminary foundation for future research investigating combined presumptive LAB and yeast-based approaches to enhance piglet gut health within sustainable livestock systems. While yeast-like isolates were detected during initial screening, they were excluded from the present analysis to maintain a clear focus on presumptive LAB and will be preserved for future yeast specific probiotic studies.
5. Conclusions
This study reports the phenotypic characterization of two bacilli-shaped presumptive LAB isolates obtained from piglet feces that exhibited tolerance to acidic and bile conditions, moderate antimicrobial activity, and limited adhesion-related properties in vitro. These findings are consistent with characteristics commonly observed during early stage screening of host adapted LAB and should be interpreted as preliminary evidence rather than confirmation of probiotic efficacy. Although the functional traits observed were modest in comparison with those reported for established commercial probiotic strains, the data provide a useful baseline for the systematic selection of candidate microorganisms for further evaluation. Accordingly, additional studies incorporating molecular identification, genome-based safety assessment, expanded antimicrobial profiling, and in vivo validation are required before any practical application can be considered. Yeast-like isolates detected during the initial screening were excluded from the present analysis to maintain a focused assessment of presumptive LAB but were preserved for future investigations targeting yeast-based probiotics. Overall, despite its inherent limitations, this preliminary study contributes to a structured framework for probiotic candidate selection in swine and supports future research aimed at developing evidence-based, sustainable alternatives to antibiotic use in livestock production.
Author Contributions
Writing—original draft, Conceptualization, Data curation, Formal analysis, Methodology, Writing—review and editing, Panuwat Yamsakul; Sample collection, Investigation, Data curation, Promporn Inyoo and Matsarina Kongton; Methodology, Laboratory, Montira Intanon and Nattakarn Awaiwanont. All authors have read and agreed to the published version of the manuscript.
Funding
This research was funded by Faculty of veterinary medicine, Chiang Mai university, Thailand.
Institutional Review Board Statement
All microbiological work was reviewed and approved by the Institutional Biosafety Committee (IBC) of Chiang Mai University (Approval No. CMUIBC A-0763004).
Informed Consent Statement
Not applicable.
Data Availability Statement
Relevant information is included in the article.
Acknowledgments
The authors also thank the faculty of veterinary medicine, Chiang Mai univer- sity, Thailand for supporting the budget.
Conflicts of Interest
The authors declare no conflict of interest.
References
- Fairbrother, J.M.; Nadeau, E.; Gyles, C.L. Escherichia coli in postweaning diarrhea in pigs: An update on bacterial types, pathogenesis, and prevention strategies. Anim. Health Res. Rev. 2005, 6(1), 17–39. [Google Scholar] [CrossRef]
- Luppi, A. Swine enteric colibacillosis: Diagnosis, therapy, and antimicrobial resistance. Porcine Health Manag. 2017, 3, 16. [Google Scholar] [CrossRef] [PubMed]
- Davis, M.E.; Maxwell, C.V.; Brown, D.C.; de Rodas, B.Z.; Johnson, Z.B.; Kegley, E.B.; Hellwig, D.H.; Dvorak, R.A. Effect of dietary mannan oligosaccharides and/or copper sulfate on growth and immunocompetence of pigs. J. Anim. Sci. 2002, 80, 2887–2894. [Google Scholar] [CrossRef]
- Moredo, F.A.; Pineyro, P.E.; Marquez, G.C.; Sanz, M.; Colello, R.; Etcheverria, A.; Padola, N.L.; Quiroga, M.A.; Perfumo, C.J.; Galli, L.; Leotta, G.A. Enterotoxigenic Escherichia coli subclinical infection in pigs: Bacteriological and genotypic characterization and antimicrobial resistance profiles. Foodborne Pathog. Dis. 2015, 12, 704–711. [Google Scholar] [CrossRef] [PubMed]
- Namkung, H.; Gong, M.; Yu, H.; Cottrill, M.; de Lange, C.F.M. Impact of feeding blends of organic acids and herbal extracts on growth performance, gut microbiota, and digestive function in weaned pigs. Can. J. Anim. Sci. 2004, 84, 697–704. [Google Scholar] [CrossRef]
- Bogere, P.; Choi, Y.J.; Heo, J. Probiotics as alternatives to antibiotics in treating post-weaning diarrhoea in pigs. S. Afr. J. Anim. Sci. 2019, 49, 403–416. [Google Scholar] [CrossRef]
- Laird, T.J.; Abraham, S.; Jordan, D.; Pluske, J.R.; Hampson, D.J.; Trott, D.J.; Dea, M.O. Porcine enterotoxigenic Escherichia coli: Antimicrobial resistance and development of microbial-based alternative control strategies. Vet. Microbiol. 2021, 258, 109117. [Google Scholar] [CrossRef]
- Boaventura, C.; Azevedo, R.; Uetanabaro, A.; Nicoli, J.; Braga, L. The benefits of probiotics in human and animal nutrition. In New Advances in Basic and Clinical Gastroenterology; Brzozowski, T., Ed.; InTech: Rijeka, Croatia, 2012; pp. 75–100. [Google Scholar] [CrossRef]
- Binns, N. Probiotics, Prebiotics and the Gut Microbiota; ILSI Europe Concise Monograph Series: Brussels, Belgium, 2013. [Google Scholar]
- Fouhse, J.M.; Zijlstra, R.T.; Willing, B.P. The role of gut microbiota in the health and disease of pigs. Anim. Front. 2016, 6(3), 30–36. [Google Scholar] [CrossRef]
- FAO/WHO. Probiotics in Food: Health and Nutritional Properties and Guidelines for Evaluation; World Health Organization: Rome, Italy, 2006. [Google Scholar]
- De Angelis, M.; Siragusa, S.; Berloco, M.; Caputo, L.; Settanni, L.; Alfonsi, G.; Amerio, M.; Grandi, A.; Ragni, A.; Gobbetti, M. Selection of potential probiotic lactobacilli from pig feces to be used as additives in pelleted feed. Res. Microbiol. 2006, 157, 792–801. [Google Scholar] [CrossRef]
- Mojgani, N.; Hussaini, F.; Vaseji, N. Characterization of indigenous Lactobacillus strains for probiotic properties. Jundishapur J. Microbiol. 2015, 8, e17523. [Google Scholar] [CrossRef]
- Ozugul, F.; Hamed, I. The importance of lactic acid bacteria for prevention of bacterial growth and biogenic amine formation: A review. Crit. Rev. Food Sci. Nutr. 2018, 58, 1660–1671. [Google Scholar] [CrossRef]
- Senok, A.C.; Ismaeel, A.Y.; Botta, G.A. Probiotics: Facts and myths. Clin. Microbiol. Infect. 2005, 11, 958–966. [Google Scholar] [CrossRef] [PubMed]
- Yu, J.; Zuo, B.; Li, Q.; Zhao, F.; Wang, J.; Huang, W.; Sun, Z.; Chen, Y. Dietary supplementation with Lactiplantibacillus plantarum P-8 improves the growth performance and gut microbiota of weaned piglets. Microbiol. Spectr. 2024, 12(2), e02345-22. [Google Scholar] [CrossRef]
- Guo, X.H.; Kim, J.M.; Nam, H.M.; Park, S.Y.; Kim, J.M. Screening lactic acid bacteria from swine origins for multistrain probiotics based on in vitro functional properties. Anaerobe 2010, 16, 321–326. [Google Scholar] [CrossRef] [PubMed]
- Ren, D.; Li, C.; Qin, Y.; Yin, R.; Du, S.; Ye, F.; Liu, C.; Liu, H.; Wang, M.; Li, Y.; Sun, Y.; Li, X.; Tian, M.; Jin, N. In vitro evaluation of the probiotic and functional potential of Lactobacillus strains isolated from fermented food and human intestine. Anaerobe 2014, 30, 1–10. [Google Scholar] [CrossRef]
- Ekmekci, H. Characterization of vaginal lactobacilli coaggregation ability with Escherichia coli. Microbiol. Immunol. 2009, 53, 59–65. [Google Scholar] [CrossRef]
- Adimpong, D.B.; Nielsen, D.S.; Sørensen, K.I.; Derkx, P.M.F.; Jespersen, L. Genotypic characterization and safety assessment of lactic acid bacteria from indigenous African fermented food products. BMC Microbiol. 2012, 12, 75. [Google Scholar] [CrossRef]
- Sirichokchatchawan, W.; Pupa, P.; Praechansri, P.; Amin, N.; Tanasupawat, S.; Sonthayanon, P.; Prapasarakul, N. Autochthonous lactic acid bacteria isolated from pig feces in Thailand show probiotic properties and antibacterial activity against enteric pathogenic bacteria. Microb. Pathog. 2018, 119, 208–215. [Google Scholar] [CrossRef]
- Petsuriyawong, B.; Khunajakr, S. Screening of probiotic lactic acid bacteria from piglet feces. Kasetsart J. Nat. Sci. 2011, 45, 245–253. [Google Scholar]
- Buxton, R. Blood agar plates and hemolysis protocols.
American Society for Microbiology
, 2005. Available online: https://asm.org https://asm.org/getattachment/7ec0de2b-bb16-4f6e-ba07-2aea25a43e76/protocol-2885.pdf.
- Dowarah, R.; Verma, A.K.; Agarwal, N.; Singh, P.; Singh, B.R. Selection and characterization of probiotic lactic acid bacteria and its impact on growth, nutrient digestibility, and health in weaned piglets. PLoS ONE 2018, 13, e0192978. [Google Scholar] [CrossRef]
- Petri, D.; Hill, J.E.; Van Kessel, A.G. Microbial succession in the gastrointestinal tract of pre-weaned pigs. Livest. Sci. 2010, 133, 107–109. [Google Scholar] [CrossRef]
- Mustakim, M.; Sinawat, S.; Salleh, S.N.; Purwati, E.; Alias, R.; Mohamad, S.A.; Mat Issa, Z. Human milk as a potential source for isolation of probiotic lactic acid bacteria: A mini review. Food Res. 2019, 4, 274–285. [Google Scholar] [CrossRef]
- Czerucka, D.; Piche, T.; Rampal, P. Yeast as probiotics-Saccharomyces boulardii. Aliment. Pharmacol. Ther. 2007, 26, 767–778. [Google Scholar] [CrossRef]
- Elghandour, M.M.Y.; Tan, Z.L.; Abu Hafsa, S.H.; Adegbeye, M.J.; Greiner, R.; Ugbogu, E.A.; Cedillo Monroy, J.; Salem, A.Z.M. Saccharomyces cerevisiae as a probiotic feed additive to non- and pseudo-ruminants: A review. J. Appl. Microbiol. 2020, 128, 658–674. [Google Scholar] [CrossRef]
- Boontiam, W.; Bunchasak, C.; Kim, Y.Y.; Kitipongpysan, S.; Hong, J. Hydrolyzed yeast supplementation to newly weaned piglets: Growth performance, gut health, and microbial fermentation. Animals 2022, 12, 350. [Google Scholar] [CrossRef] [PubMed]
- Canibe, N.; Højberg, O.; Kongsted, H.; Vodolazska, D.; Lauridsen, C.; Nielsen, T.H.; Schönher, A.A. Preventive measures to reduce post-weaning diarrhoea in piglets: A review. Animals 2022, 12, 2585. [Google Scholar] [CrossRef]
- Yeo, S.; Lee, S.; Park, H.; Shin, H.; Holzapfel, W.; Huh, C.S. Development of putative probiotics as feed additives: Validation in a porcine-specific gastrointestinal tract model. Appl. Microbiol. Biotechnol. 2016, 100, 10043–10054. [Google Scholar] [CrossRef] [PubMed]
- Gotcheva, V.; Hristozova, E.; Hristozova, T.; Guo, M.; Roshkova, Z.; Angelov, A. Assessment of potential probiotic properties of lactic acid bacteria and yeast strains. Food Biotechnol. 2002, 16, 211–225. [Google Scholar] [CrossRef]
- Wang, H.; Xu, R.; Zhang, H.; Su, Y.; Zhu, W. Swine gut microbiota and its interaction with host nutrient metabolism. Anim. Nutr. 2020, 6, 410–420. [Google Scholar] [CrossRef]
- Wang, M.; Zhou, X.; Birch Hansen, L.H.; Sheng, Y.; Yu, B.; He, J.; Yu, J.; Zheng, P. Complex probiotics reduce diarrhea by enhancing immunity and balancing gut microbiota in weaned piglets. Front. Immunol. 2025, 16, 1629044. [Google Scholar] [CrossRef]
- Garcia-Cayuela, T.; Korany, A.; Bustos, I.; Cadinanos, L.; Requena, T.; Pelaez, C.; Martinez-Cuesta, M.C. Adhesion abilities of dairy Lactobacillus plantarum strains showing an aggregation phenotype. Food Res. Int. 2014, 57, 44–50. [Google Scholar] [CrossRef]
- Chokesajjawatee, N.; Santiyanont, P.; Chantarasakha, K.; Kocharin, K.; Thammarongtham, C.; Lertampaiporn, S.; Vorapreeda, T.; Srisuk, T.; Wongsurawat, T.; Jenjaroenpun, P.; Nookaew, I.; Visessanguan, W. Safety assessment of a Nham starter culture Lactobacillus plantarum BCC9546 via whole-genome analysis. Sci. Rep. 2020, 10, 10241. [Google Scholar] [CrossRef]
- Anadón, A.; Martínez-Larrañaga, M.R.; Martínez, M.A. Probiotics for animal nutrition in the European Union: Regulation and safety assessment. Regul. Toxicol. Pharmacol. 2006, 45, 91–95. [Google Scholar] [CrossRef]
- Zendeboodi, F.; Khorshidian, N.; Mortazavian, A.M. Probiotic: Conceptualization from a new approach. Curr. Opin. Food Sci. 2020, 32, 103–123. [Google Scholar] [CrossRef]
- Qiao, J.; Li, H.; Wang, Z.; Wang, W. Effects of Lactobacillus acidophilus dietary supplementation on performance, intestinal barrier function, rectal microflora, and serum immune function in weaned piglets challenged with Escherichia coli lipopolysaccharide. Antonie Van Leeuwenhoek 2015, 107, 883–891. [Google Scholar] [CrossRef] [PubMed]
- Lu, X.; Zhang, M.; Zhao, L.; Ge, K.; Wang, Z.; Jun, L.; Ren, F. Growth performance and post-weaning diarrhea in piglets fed diets supplemented with probiotic complexes. J. Microbiol. Biotechnol. 2018, 28, 1791–1799. [Google Scholar] [CrossRef] [PubMed]
|
Disclaimer/Publisher’s Note: The statements, opinions and data contained in all publications are solely those of the individual author(s) and contributor(s) and not of MDPI and/or the editor(s). MDPI and/or the editor(s) disclaim responsibility for any injury to people or property resulting from any ideas, methods, instructions or products referred to in the content. |
© 2026 by the authors. Licensee MDPI, Basel, Switzerland. This article is an open access article distributed under the terms and conditions of the Creative Commons Attribution (CC BY) license (http://creativecommons.org/licenses/by/4.0/).